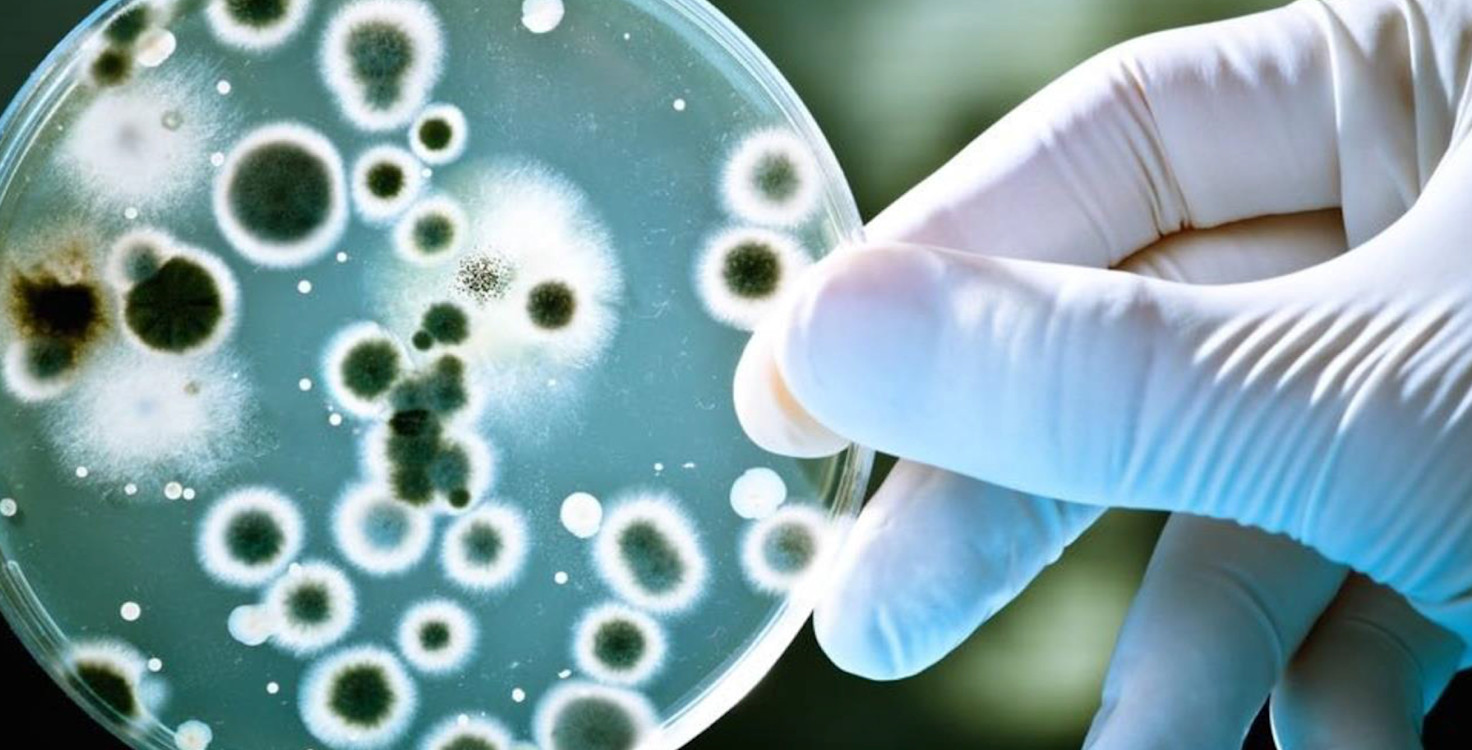
Food-Safety-10.jpg

A global coalition of 77 stakeholders with $569 billion in assets under management is urging the private sector to take critical action to address antimicrobial resistance. Investors are asking companies to implement stricter policies on antibiotic use in livestock supply chains.
“We urge that the role of the animal health, food and agriculture industry is not overlooked and encourage the private sector to take critical action,” reads the investor statement.
On Wednesday, the UN will host a High-Level Meeting on Antimicrobial Resistance at its headquarters in New York. The meeting will bring together Member States, non-governmental organisations, civil society, the private sector and academic institutions.
“[We] call on UN member states to bring clarity to antibiotic use recommendations currently in place through the implementation of stringent national and regional regulations, which will ensure that public health sits firmly at the heart of the food system,” the statement continues.
“As shareholders we urge animal health and food companies, including meat producers, restaurants and retailers, to end the use of antibiotics important to human medicine in their operations and global supply chains.”
Investors include: Mirova; Strathclyde Pension Fund; Coller Capital; Menhaden Capital; and Trillium Asset Management.
Earlier this year, a coalition of investors worth over $1 trillion in assets wrote to 10 leading US and UK fast food and restaurant companies, to raise concerns about antimicrobial resistance. They asked the companies to phase out the routine use of medically important antibiotics in their meat and poultry supply chains. Investors are in continued dialogue with eight of the companies.
Click here to see the full statement.
Notes for editors:
The full statement and list of signatories can be accessed here: https://shareaction.org/wp-content/uploads/2016/09/InvestorStatementAntimicrobialResistance.pdf
The statement has been developed by ICCR, the FAIRR Initiative, ShareAction and As You Sow.
FAIRR and ShareAction are working with investors to encourage progress towards a sustainable food system, through challenging risks and promoting opportunities for companies to build resilient food chains.
For more information contact Rosie Wardle at rosie.wardle@fairr.org, or Grace Hetherington at Shareaction (grace.hetherington@shareaction.org or 07746130912)